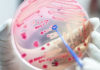
Sepse: importância do diagnóstico precoce e preocupação com a COVID-19 SEPSE

Acontece neste sábado, dia 06, a partir das 14h no Parque de Exposições Artur Hoffig, em Cornélio Procópio, Feira da Economia Local promovido pelo Sicredi Paranapanema Serrana. No evento haverá diversas atividades, assim como praça de alimentação e produtos da região, além de palestras inspiradoras como a de Tiago Linck ‘Uma Vida Sem Limites’; Devanilde Arias ‘Mulheres que Mudam o Mundo’; Marco Morato ‘A Importância das Energias Renováveis’; Ainor Loterio ‘A Importância da Diversificação na Produção’; e Ana Patrícia Misael ‘A Prática da Comunicação Assertiva’.
 A realização do evento tem como finalidade promover e fortalecer a economia local, reunindo empreendedores e associados para expor e vender seus produtos e serviços, sendo um espaço para troca de aprendizado e conexões, além de oferecer palestras sobre empreendedorismo, desenvolvimento econômico e social, e energia renovável.
A realização do evento tem como finalidade promover e fortalecer a economia local, reunindo empreendedores e associados para expor e vender seus produtos e serviços, sendo um espaço para troca de aprendizado e conexões, além de oferecer palestras sobre empreendedorismo, desenvolvimento econômico e social, e energia renovável.
O evento tem sido realizado em diferentes cidades de atuação do Sicredi e é aberto ao público.